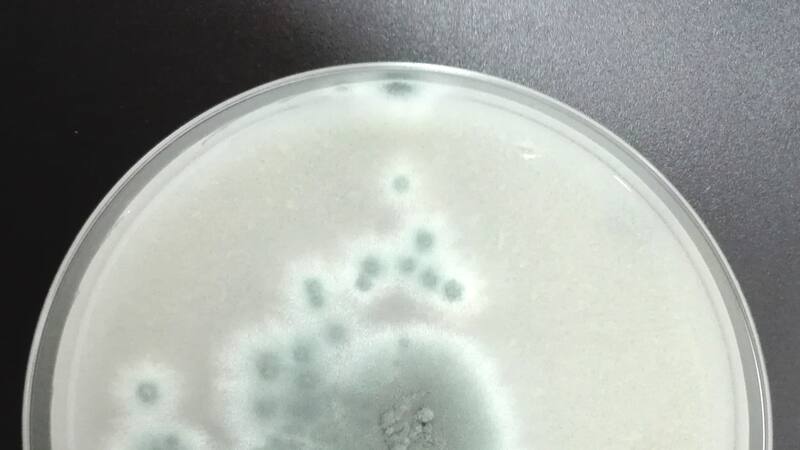

OMS publica lista de hongos potencialmente mortales: cuatro de los más letales están en Chile
De acuerdo a la organización, estos microorganismos provocan la muerte de más de 1,6 millones de personas al año y causan enfermedades a largo plazo en cientos de millones más.
“Alrededor de 350 mil personas en Chile sufren de una micosis potencialmente letal”, advierte Eduardo Álvarez Duarte, investigador del Instituto de Ciencias Biomédicas de la Universidad de Chile y representante en nuestro país de la “Acción Mundial para las Infecciones Fúngicas” (GAFFI), quien detalla que cuatro de los patógenos que la Organización Mundial de la Salud (OMS) acaba de poner en una lista categorizados como de importancia crítica, están presentes en Chile.
El académico explica que algunos de estos hongos causantes de enfermedades graves se han expandido por el mundo (Candida auris) y que uno de los principales problemas asociados a ellos es el desarrollo de resistencia a fármacos antifúngicos. Agrega que en los últimos años se ha podido comprobar que dos especies de esta lista corresponden a micosis importadas desde zonas tropicales y subtropicales.
Cryptococcus neoformans, Aspergillus fumigatus, Candida albicans y Candida auris fueron los cuatro hongos de importancia crítica que entraron en la “lista negra” de patógenos fúngicos publicada recientemente por la OMS, especies asociadas a enfermedades graves como la meningitis, infecciones de distintos órganos y sistémicas y a la resistencia a los antimicóticos, este último, un fenómeno de creciente preocupación global. Esta “Lista de patógenos fúngicos prioritarios” la integran -en total- 19 tipos de hongos categorizados como de prioridad “crítica”, “alta” y “media”, organismos de importancia médica que provocan la muerte de más de 1,6 millones de personas al año y causan enfermedades a largo plazo en cientos de millones más.
Eduardo Álvarez Duarte afirma que “esta lista prioritaria de hongos de importancia médica es crucial para el mundo y, por supuesto, para nuestro país. Por primera vez en la historia, se coloca el foco en hongos que causan una serie de enfermedades, muchas veces silentes. El número real de estas infecciones en Chile es desconocido, por lo que el real impacto a nivel local no se conoce con certeza. De hecho, el único esfuerzo nacional fue realizado junto a GAFFI el año 2017, donde estimamos que alrededor de 350.000 chilenos al año sufren de una micosis potencialmente letal”.

De acuerdo al documento publicado por la OMS, “esta lista está centrada en los patógenos fúngicos responsables de micosis sistémicas agudas y subagudas para las que existe resistencia a los medicamentos u otros problemas de terapéutica y gestión o, dada su prevalencia. Los patógenos incluidos están todos asociados con graves riesgos de mortalidad y/o morbilidad”, particularmente entre la población inmunocomprometida, como las personas de mayor edad o pacientes diabéticos, VIH/SIDA o con cáncer, entre muchas otras afecciones. Eduardo Álvarez precisa que la definición de estos patógenos como prioritarios se estableció básicamente en función de cuatro parámetros críticos: prevalencia en la población, mortalidad asociada, resistencia a antifúngicos y acceso al diagnóstico.
Uno de los hongos críticos es Cryptococcus neoformans, “que tiene una alta prevalencia a nivel mundial, y una mortalidad que oscila entre un 40 y 60%. Este es un microorganismo con el que hay que tener ojo. Las meningitis fúngicas son un tema importante, sobre todo considerando que los pacientes inmunocomprometidos van al alza. Tenemos una masa de pacientes en esta categoría, personas mayores y con enfermedades de base, que crece, así como las expectativas de vida y la población envejecida”, señala el especialista. Además, el acceso al diagnóstico de esta micosis en otras latitudes, como algunos países de África, es difícil, en circunstancias de que es una técnica cuyo costo aproximado no supera los US$5.
Otro de los hongos incluidos en la categoría de críticos es Candida albicans, que si bien presenta una resistencia a los antifúngicos más bien baja, “registra una mortalidad asociada, de entre un 20 a 40%. Algunos autores hablan de entre un 20 a 50%, es decir, es un hongo con el que hay que tener ojo por su índice de mortalidad. También es uno de los hongos que produce más infecciones fúngicas, es muy prevalente”.
Alerta por resistencia a los antifúngicos
El académico de la Universidad de Chile destaca que 14 de los 19 hongos incorporados a esta lista actualmente están en el país, incluyendo los cuatro calificados como de importancia crítica. Advierte, además, que algunos de estos se han expandido por el mundo cada vez con mayor intensidad, gracias al desarrollo del turismo a escala global y los procesos migratorios. De hecho, dos de las especies de hongos encontradas recientemente en Chile corresponden a micosis importadas desde zonas tropicales y subtropicales: Candida auris (categorizado como crítico) e Histoplasma capsulatum. Respecto a esta última especie, “ya hemos diagnosticado cerca de 40 casos de esta micosis importada. Candida auris, en tanto, apareció hace un par de años en nuestro país y ha generado alarma por su alta resistencia a los antifúngicos y a compuestos que se ocupan como desinfectantes ambientales. Esta capacidad le ha permitido instalarse en ambientes intrahospitalarios y provocar brotes”, advierte Álvarez.
La resistencia a los antifúngicos es uno de los aspectos de mayor preocupación global. Esta propiedad puede estar asociada a capacidades específicas de cada especie de hongo, como es el caso de Candida auris, pero también puede desarrollarse por el uso indiscriminado de los pocos antifúngicos existentes. Tal es el caso de los azoles, fármacos que se utilizan como antimicóticos en humanos, pero también en la agricultura, por ejemplo, para el control de Aspergillus fumigatus, que vive en ambientes de prácticamente todo el mundo. De acuerdo al representante de GAFFI en Chile, este hongo de prioridad crítica, que puede provocar infecciones respiratorias como la aspergilosis, “ha presentado mutaciones en algunos de sus genes y muchas de ellas se relacionan con la resistencia a los antifúngicos que se ocupan en la agricultura. Es un mecanismo de adaptación, de evolución, que el hongo ha desarrollado para seguir viviendo”, explica.

El problema es que esta resistencia desarrollada en la agricultura finalmente también afecta a los tratamientos que se ocupan en humanos, especialmente en pacientes inmunocomprometidos. Este fenómeno, conocido como resistencia cruzada, implica que “si un paciente desarrolla una infección por este hongo que se hizo resistente a los azoles por su utilización en la agricultura, se puede hacer resistente a los azoles utilizados en humanos y ya no habrá con qué tratarlo. Significa que si se complica puede morir”. A esto, se agrega la posibilidad de que las capacidades de resistencia puedan traspasarse entre distintos hongos, tal como ocurre con las bacterias. “Por mucho tiempo se pensaba que estos mecanismos no estaban presentes en hongos. No obstante, hay algunos estudios que han demostrado que entre hongos sí hay intercambio de información genética, por lo que no podemos descartar que existiese un traspaso de información genética codificante de resistencia, aunque probablemente no es el mecanismo más usual”, plantea.
Recomendaciones de la OMS
La organización “Acción Mundial para las Infecciones Fúngicas (GAFFI)” ha trabajado con la OMS durante varios años para incluir a todos los antifúngicos y métodos de diagnóstico clave en las Listas de Diagnósticos Esenciales y de Medicamentos Esenciales. “Las enfermedades fúngicas son una amenaza mundial, con una gran desigualdad en el acceso a diagnósticos y medicamentos antifúngicos que pueden salvar vidas. El compromiso de la salud pública, con la integración de los diagnósticos en la atención rutinaria, tiene el potencial de salvar innumerables vidas cada año. El compromiso de la OMS es fundamental para mejorar la salud mundial y hacer frente al creciente espectro de la resistencia a los antifúngicos”, sostiene David Denning, director ejecutivo de GAFFI.
La lista elaborada por la OMS tiene como objetivo impulsar nuevas investigaciones e intervenciones políticas tendientes a reforzar la respuesta mundial a las infecciones fúngicas graves, colocando especial atención a la resistencia a los antifúngicos. “Afortunadamente, en Chile tenemos un sistema de diagnóstico de las micosis bien implementado, lo que nos permite realizar diagnósticos certeros y rápidos. Esto contribuye enormemente a la proyección exitosa de la infección en los pacientes, disminuyendo la letalidad. Este sistema evidentemente funciona bien en grandes ciudades, pero posiblemente aún falte en las ciudades más pequeñas o extremas”, comenta el profesor Álvarez respecto a la situación del país.
Indica también que “es importante visibilizar el problema, extender la red diagnóstica y -por sobre todo- generar las instancias educativas y de formación de capital humano competente en la materia, labor que venimos realizando desde nuestro laboratorio en los últimos años”. Uno de los aspectos centrales, señala, es la educación de la población para evitar que las personas se automediquen, mal utilicen antifúngicos y prevenir así que los hongos desarrollen mecanismos de resistencia. “También medidas tendientes a hacer un uso racional de los antifúngicos en la agricultura, normas para el uso racional de antifúngicos en seres humanos y animales, y la disposición de fondos para proyectos que -por ejemplo- permitan la búsqueda de nuevos antifúngicos, ya que hoy tenemos entre 10 y 12, no más que eso. Entonces, es necesario hacer mayor investigación al respecto”, concluye.
Áreas de actuación recomendadas:
● Mejorar la vigilancia de las enfermedades fúngicas (que requiere un acceso regular a los diagnósticos).
● Apoyo específico a I+D e innovación (nuevos medicamentos antimicóticos, mejora de los diagnósticos).
● Mejorar sistemas sanitarios (para garantizar el acceso al diagnóstico, la detección de resistencias y la terapia, incluyendo un importante aumento de la formación).
● El informe además sugiere y demanda el acceso universal a estas pruebas diagnósticas y terapias antifúngicas.
COMENTARIOS
Para comentar este artículo debes ser suscriptor.
Lo Último
Lo más leído
1.
2.
3.
4.